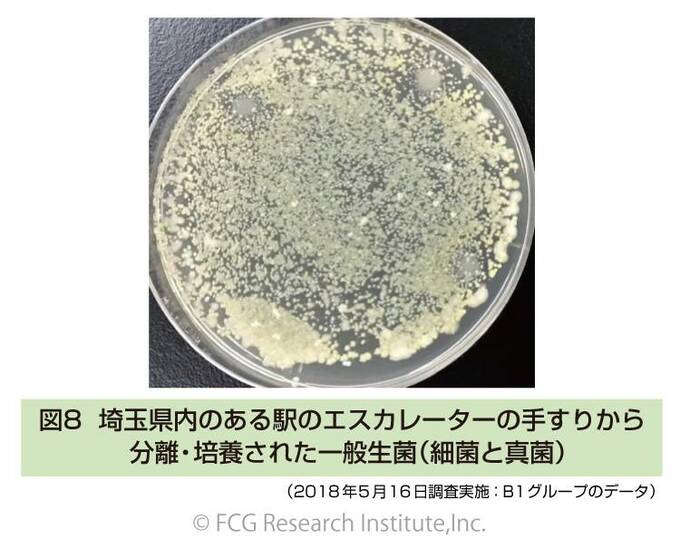
培養された一般生菌

スマートフォンやタブレットなどのデバイスを介して、新型コロナウイルス感染が広まるおそれが指摘されています。
長年に渡って一般住宅、大学病院、老人介護施設など異なる環境に存在する「真菌・細菌・ダニ・微小昆虫」などを総合的に調査・研究してきた博士(農学)の川上裕司さんも、「スマートフォン感染は他人事ではないと考えた方が賢明です」と話します。以下、詳細を寄稿していただきました。
新型コロナウイルスのスマートフォン感染に注意が必要
国の緊急事態宣言によって、朝夕の通勤電車内の乗客の数も明らかに減少しました。しかしながら、朝の通勤快速の車内では、密集状態が完全に緩和されたというところまではいっていません。筆者は、新型コロナウイルス感染症が国内で増え始めた当初から、公共交通機関の車内でよく見られる行為が感染経路として気になっていました。
それは、「車内のつり革や手すりを握りながらのスマートフォンの操作」です。
ここでは、未発表の調査データを踏まえて、その危険性について解説します。
●公共交通機関のエスカレーターやつり革の手すりの汚染事例
2018年に、環境微生物の公共の場所での汚染実態を調べることを目的として、公共交通機関のエスカレーターとつり革にどのくらい付着しているか調べてみました。
これは、内部の調査資料として表に出なかったデータです。新型コロナウイルス感染症対策のための手洗いの重要性を強く啓発するために、ここで紹介することにしました。
外部環境からの手指の微生物汚染が絵空事ではないことを具体的に示すためのもので、読者をいたずらに脅かすためではなく、公共交通機関の衛生管理を非難するものではないことをはじめに申し上げておきます。
調査は、2018年5月16日と23日に実施しました。東京都所在の3つの駅、埼玉県所在の2つの駅、千葉県所在の1つの駅、合計6つの駅のエスカレーターの手すりを調査対象として、微生物汚染度を調べました。それぞれ、生理食塩水を含ませた化粧用コットンでふき取り(約50㎠)、一般生菌数用培地を用いた混釈法で付着している生菌数(一般的な細菌と真菌の数)を調べました。
この結果、エスカレーターの手すりに普通に手でつかまったくらいの面積に、[1,700~300,000個(10
3~105)/約50㎠]の細菌や真菌(カビやコウボ)が付着していることがわかりました(図8参照)。
<つり革の微生物調査>調査は、2018年7月6日に実施しました。東京都内のある路線に乗車して、つり革の手を握る部分(約40㎠)について、微生物汚染度を調べました。4つのつり革(A・B・C・D)を調査対象とし、4つとも最初に生理食塩水を含ませた化粧用コットンでふき取り、最初のサンプル(A‐1、B‐1、C‐1、D‐1)としました。
次に、4つのつり革のうち2つ(CとD)を消毒用エタノールで拭いて除菌しました。1時間経過後、4つのつり革から同様にサンプリングを行い、2回目のサンプル(A‐2、B‐2、C‐2、D‐2)としました。各サンプルは、一般生菌数用培地を用いた混釈法で付着している生菌数(一般的な細菌と真菌の数)を調べました。
また、調査の際に、つり革につかまった乗客の数を計数しました。
図9に結果を示します。1時間の間につり革につかまった乗客の人数は、Aのつり革では3名(男性2名・女性1名)で、B・C・Dのつり革ではそれぞれ女性1名でした。
一般生菌数にはバラツキが見られましたが、Bのつり革のように、1名の乗客がつかまっただけで、80個/約40㎠の生菌数から54,000個/約40㎠へ菌数が急増する場合があることが示唆されました。また、CとDのつり革のように消毒用エタノールで除菌しても乗客が1名つかまると、最初の菌数と同じくらいの生菌数となる傾向が示唆されました。
これら2つのデータは、あくまで寒天培地で培養可能な細菌と真菌を調べたデータです。エスカレーターの手すりやつり革には抗菌素材が使用されていることが多く、また、清掃担当者が、日々、殺菌消毒処理を実施しています。付着菌数は、季節やその日の乗降客数にも影響されます。
しかしながら、これらのデータは不特定多数の人々が接触するエスカレーターの手すりやつり革は、微生物がヒトからヒトへ移る可能性が高いことを示す指標になります。
●汚染した手指からスマートフォンへの新型コロナウイルスの移染
これまでの解説を踏まえて、図10をご覧ください。スマートフォンへの新型コロナウイルスの移染、そして、最悪の場合、帰宅してすぐに十分な手洗いを行ったとしても、スマートフォンを見ながら食事をすることで、感染する危険性があることがおわかりいただけると思います。
読者ご自身の日常の行動を振り返り、新型コロナウイルスの感染リスクがあることは、極力避ける努力をすることが今やるべきことの1つです。多分大丈夫だろうと考えて(あるいはまったく考えないで)、これまでなにげなく行ってきた行為が、感染経路不明者が増加している一因ではないでしょうか。
ではどうすればいいのか? 二者択一ですので、どちらかを各自が履行するしかないでしょう。
・公共交通機関を利用する際には(車内では)、スマートフォンの操作を控える。 ・自分はスマホ中毒で、車内でスマートフォンを操作しないとストレスになるという方は、帰宅直後や職場に着いた時点で、手指と同時にスマートフォンも消毒する。なお、公共交通機関では乗車の際に、急ブレーキや揺れた際の危険防止のため、つり革や手すりにつかまることをアナウンスしています。感染が怖いからつかまるのはやめておこうという考えは(その気持ちは筆者もよく解りますが)、ここでは推奨しません。
四六時中、スマートフォンを手放せない方は、流水洗浄が可能な防水スマートフォンであれば、手洗いと同時に水洗いをしましょう。防水タイプでない多くのスマートフォンは、十分に消毒用エタノールを含ませたティッシュペーパーでふくことをおすすめします。